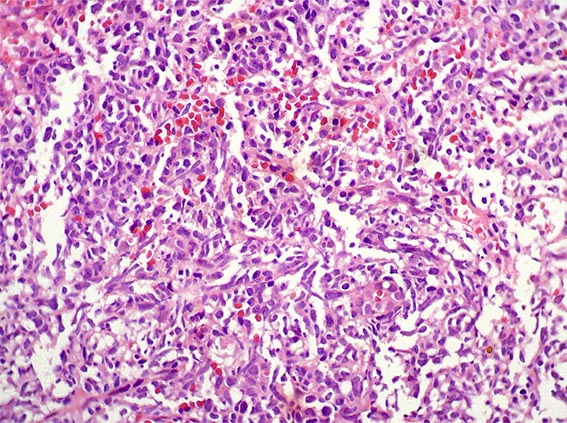
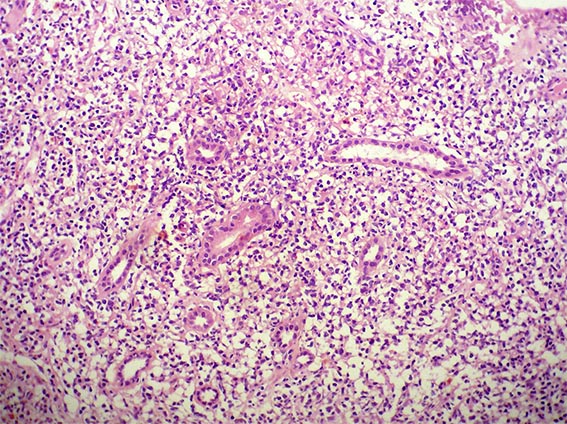

|
|
CASE
113 (July 2015)
Clinical information
The patient is a 41-year-old woman with constitutional symptoms. Among the many studies undertaken to determine its cause, pyuria and microscopic hematuria were found in the urinary sediment, and, by ultrasonography, a ill-defined mass was evidenced on the renal upper pole of the left kidney.
A biopsy of the mass was obtained. See the images.

Figure 1. H&E, X200.

Figure 2. H&E, X400.
Figure 3. H&E, X400.

Figure 4. H&E, X400.

Figure 5. H&E, X400.
Figure 6. H&E, X200.
What is your diagnosis?
See
diagnosis and discussion
[Top]
|
|